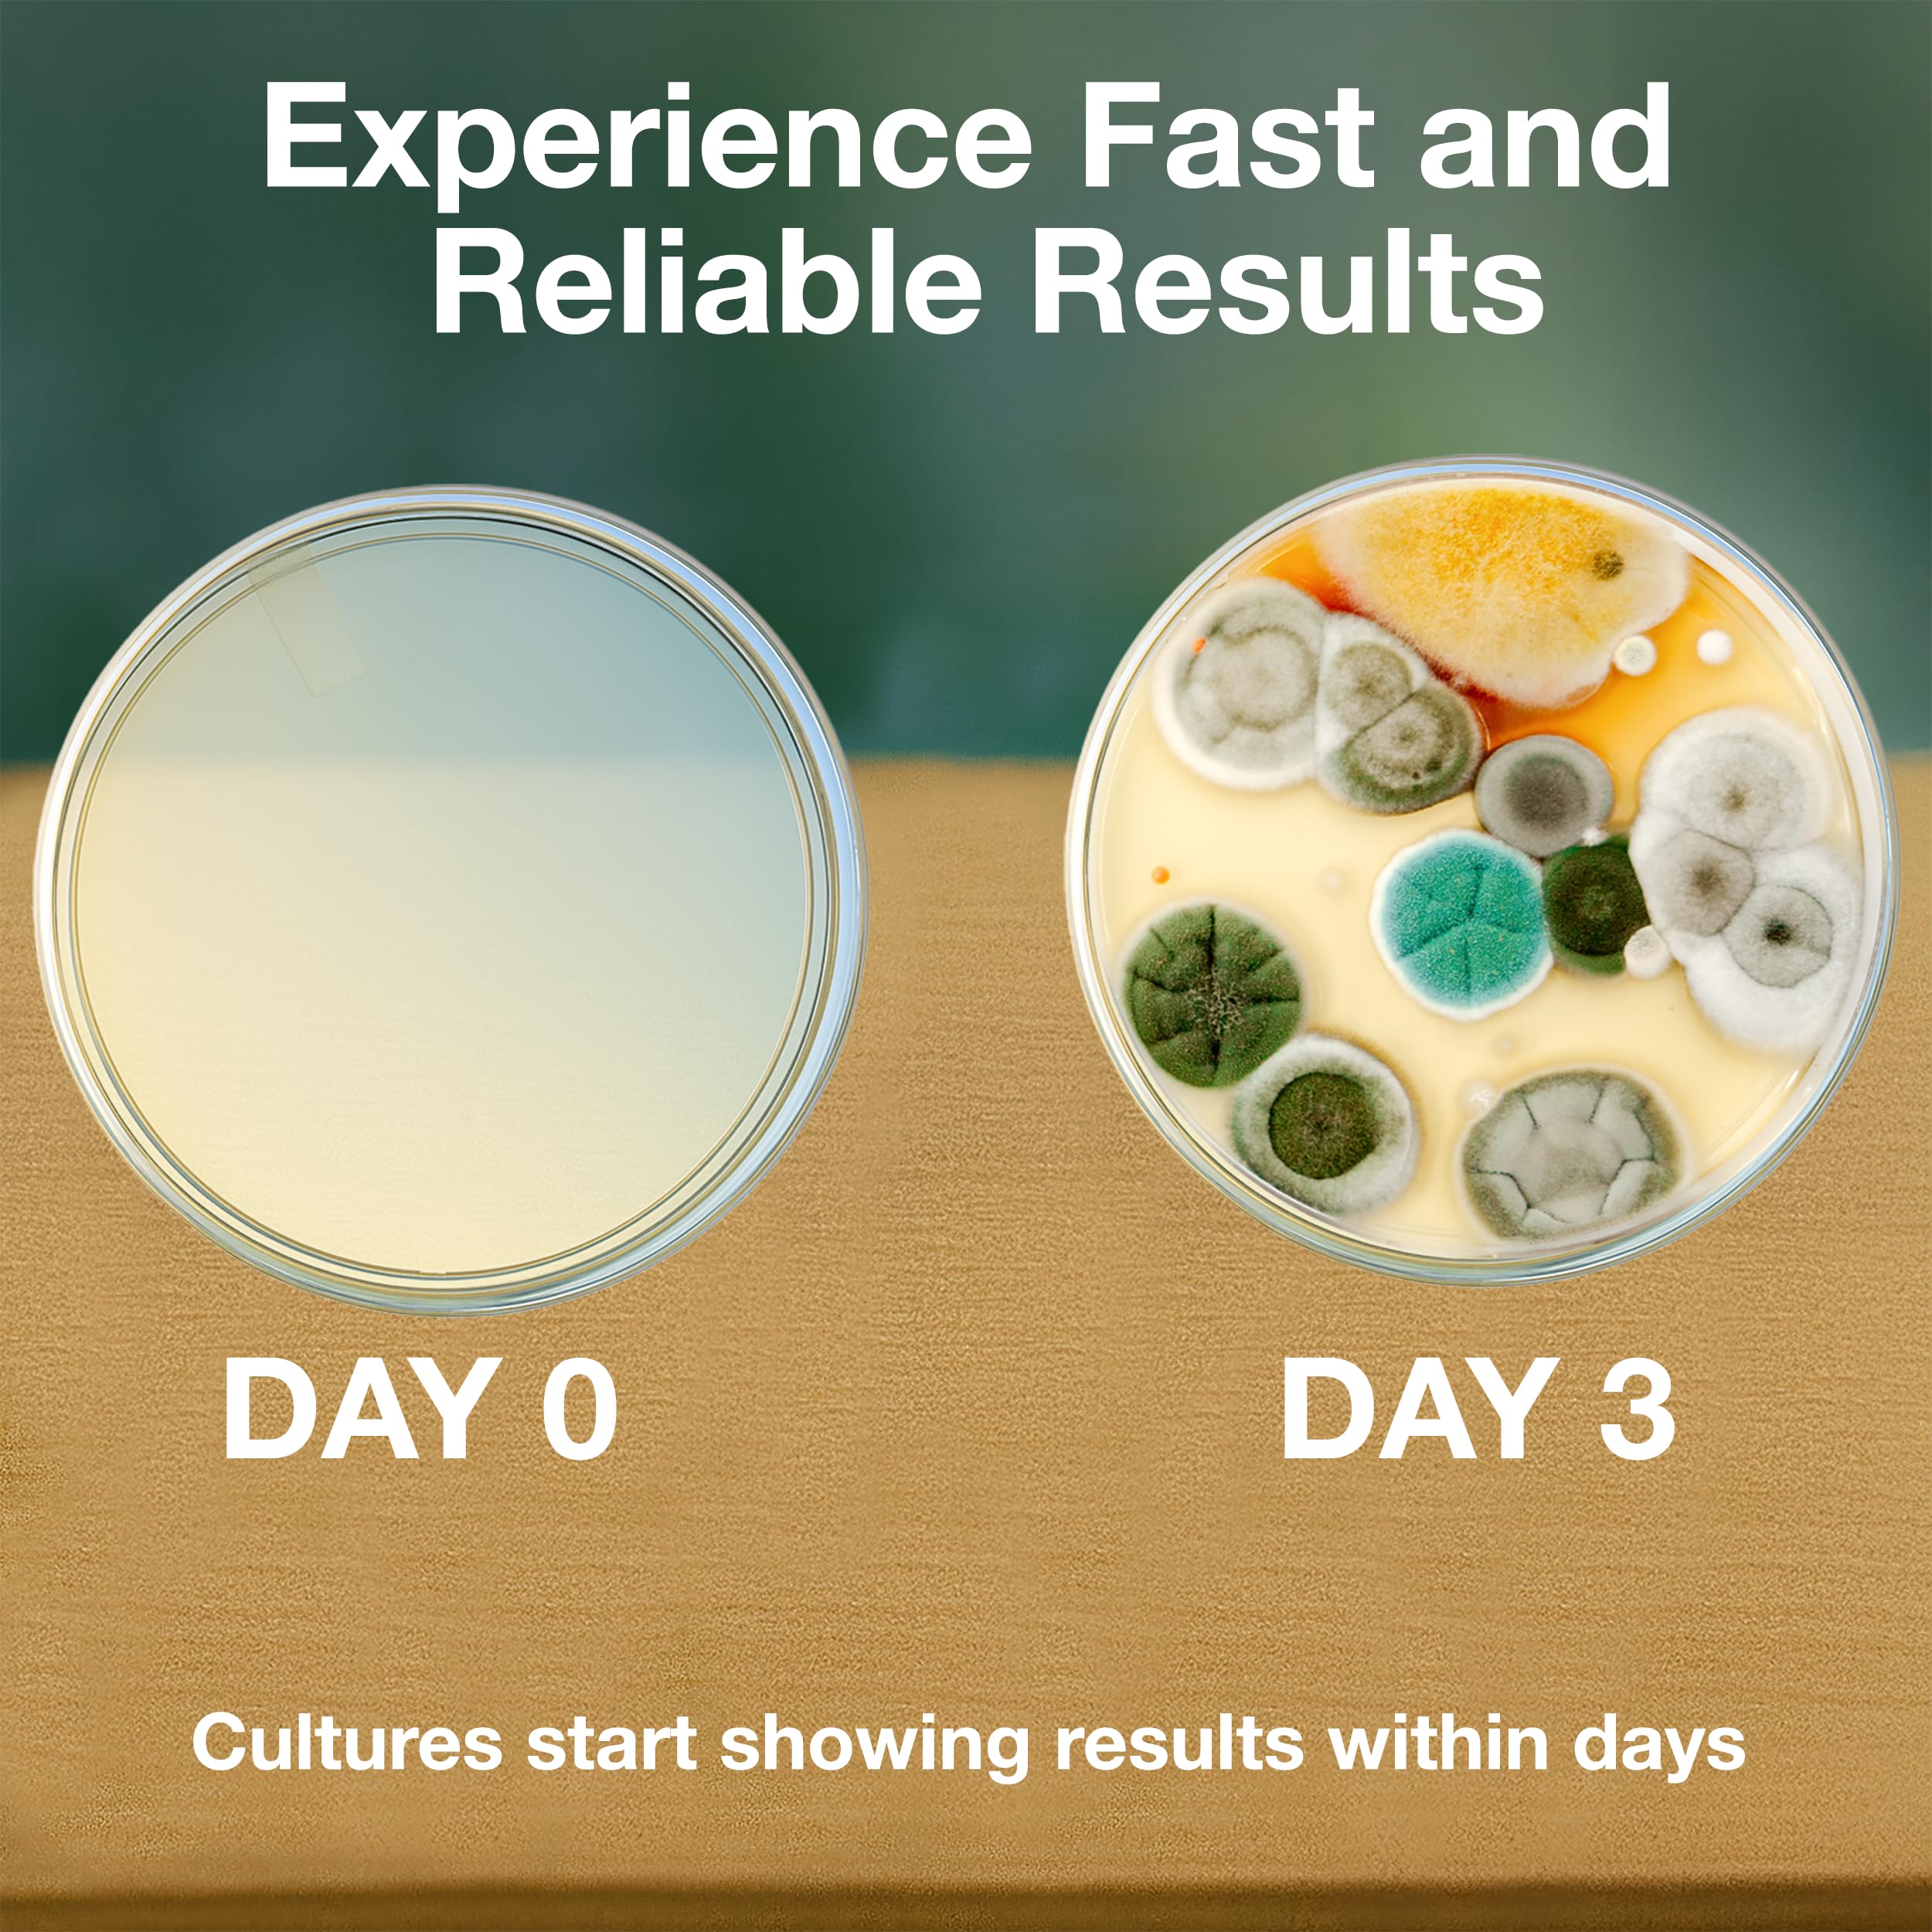
Thumbnail 8

🔍 Discover the Microbiologist in You!
The ES EVVIVA SCIENCES Amazing Bacteria Kit is an award-winning educational tool designed for budding scientists. It includes 10 pre-poured agar plates, essential tools for experimentation, and a comprehensive ebook filled with exciting projects. Manufactured to the highest industry standards, this kit ensures optimal bacteria growth while providing a safe and convenient learning experience. Plus, with a 100% money-back guarantee, it's a risk-free investment in science education!






| Product Dimensions | 15.24 x 10.16 x 10.16 cm; 402.56 g |
| Item model number | LYSB00W4XHF3G-TOYS |
| Educational Objective(s) | Science |
| Language: | English |
| Assembly Required | No |
| Batteries Required? | No |
| Batteries Included? | No |
| tech_spec_battery_description_toys | Not Applicable (batteries not required) |
| ASIN | B00W4XHF3G |
ترست بايلوت
منذ أسبوع
منذ 4 أيام